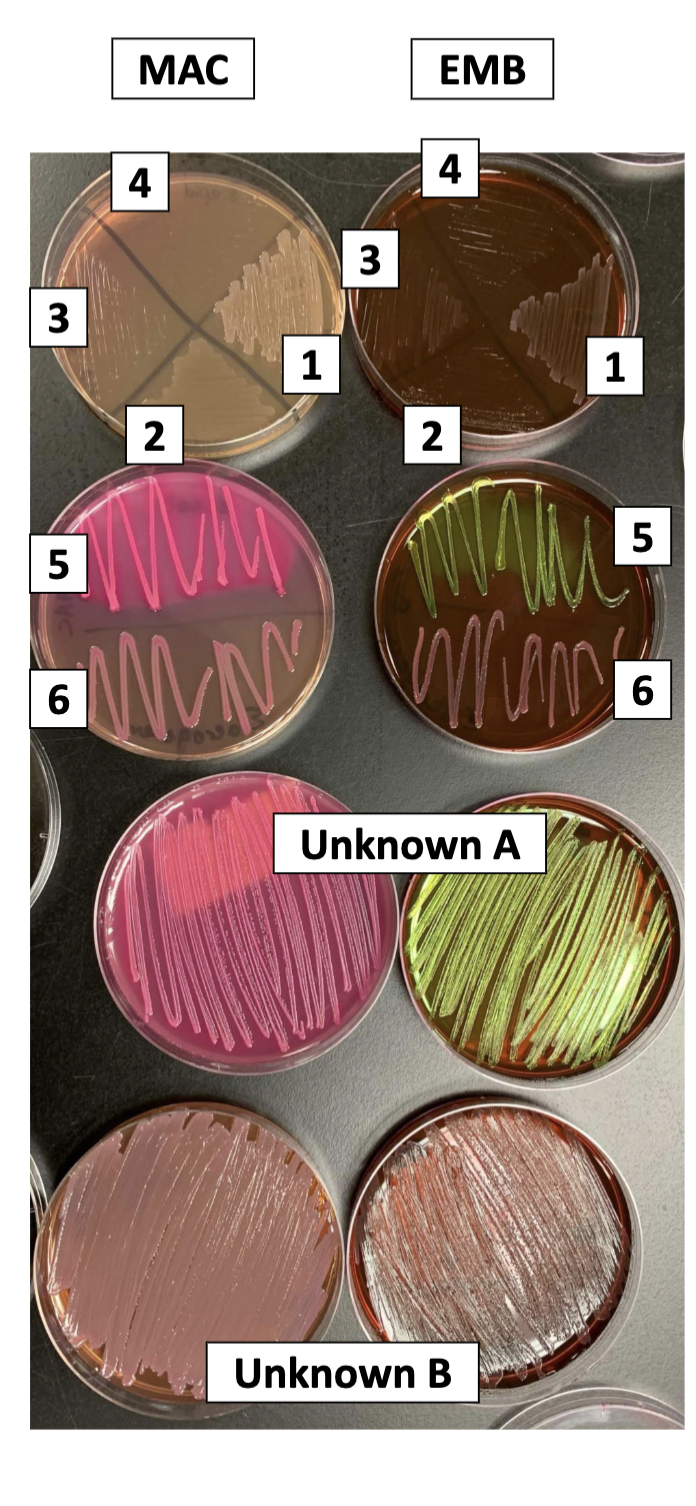
<p>MAC plate:</p><p>1 + 2 are gram negative while 4+3 must be gram positive</p><p>1 and 2 cannot ferment lactose (no color change)</p><p>5=there is growth (gram negative) and a color change to pink=ferments lactose to acids</p><p>6=growth but no color change so does not ferment lactose to acids</p><p>unknown A is gram negative and ferments lactose</p><p>unknown B does not ferment lactose but is gram negative</p><p></p><p>EMB:</p><p>1+2  are gram negative and does not ferment lactose to acids</p><p>3+4 are gram positive </p><p>5 is gram negative and can ferment lactose to acids (green may mean pH of less than or equal to 4.8)</p><p>6 is gram negative but cannot ferment lactose to acids (no color change)</p><p>unknown A is gram negative and can ferment lactose to acids</p><p>unknown B is gram negative and cannot ferment lactose to acids</p>

1/101
Looks like no tags are added yet.
Name | Mastery | Learn | Test | Matching | Spaced | Call with Kai |
|---|
No analytics yet
Send a link to your students to track their progress
Extremophile
microbes that can grow at harsh conditions (ex: boiling mud pits or the Arctic circle)
phile ending means
they like it
phobic ending means
they dont like it
what are the different categories of growth conditions we looked at for microbes (4)
temperature, pH, water availability, and oxygen tolerance (aerotolerance)
what is a hyperthermophile
70 degrees and upwards
what is a thermophile
optimal growth between 45 and 70 degrees
what is a mesophile
25 and 45 degrees C (human body is 37 degrees C)
what is a psychrotroph?
prefers 15-30 degrees C
what is a psychrophile
between -5 and 15 degrees C
what is a neutrophile
organisms that thrive in neutral (pH 7) environments
what is an alkaliphile
microbes that thrive in alkaline (pH 8.5 and greater) environments
what is an acidophile
microbes that like acidic conditions (pH of 5.5 or below)
what is a halotolerant microbe
organisms that survive up to 10% solute concentration
what is a halophile
organisms that require high solute concentrations to grow, like marine bacteria that need 3% sodium chloride
what are aerobic microbes
organisms that require oxygen to grow
what are aerotolerant microbes
organisms that do not use oxygen but can grow in its presence (do not use it but are not like strict anaerobes that will literally die in the presence of oxygen)
what are microaerophile microbes
organisms that have small amounts of oxygen to grow
what are facultative anaerobes
microbes that use oxygen to grow but can grow without it as well
what are anaerobes
organisms that cannot grow in the presence of oxygen (like at all)
design an experiment to test for temperature conditions/determine if your unknown culture grows at the temperatures 4 degrees C, 37 degrees C, and 50 degrees C
get one plate with a thermophile (put at 50 degrees) and a mesophile (put at 37 degrees), and preferably a psychrophile (can grow between -5 and 15 degrees C so put at 4 degrees C)
these will serve as your controls. then grab three of the same kind of plates, and swab your unknown on them. place one of your unknowns in one of the three conditions for each one, and then, observe microbial growth afterwards
*make sure you control everything else besides temperature, like incubation time, pH, aerobic conditions, and type of TSAYE plate
design an experiment to test for pH/see if your unknown culture grows at pH 2, 6, or 10
establish your controls: preferably an acidophile, neutrophile, and alkaliphile
have your acidophile on pH of 2, neutrophile on pH of 6, and alkaliphile at pH of 10. these will serve as your controls to help you determine what pH conditions your microbe likes to grow in
swab your unknown on a pH plate of 2, 6, and 10. then, have it incubate for the same amount of time as the others
*control your temperature, incubation time, aerobic conditions, and type of plate (TSAYE)
design an experiment that tests for whether your unknown grows at 0%, 10%, and 25% NaCl
get TSBYE tubes with 0%, 10%, and 25% NaCl
obtain a halotolerant) and a halophile (needs high solute concentration to grow)
obtain a halotolerant (maybe one that cannot grow up to 10%), a halolerant than can grow at 10%, and a halophile. put the first halotolerant one in a TSBYE of 0%, the second one in a TSBYE of 10%, a halophile at 10% (shows what a halophile looks like at 10% vs a halotolerant), and a halophile at 25%.
take your unknown and inoculate it in each of the three different osmotic conditions. compare them to your standards
the reason behind a halotolerant and a halophile at 10% is because a halotolerant will likely exude weak growth while the halophile will have stronger growth→if your unknown has stronger growth a 10%, then it is one additional piece of evidence on whether it is halotolerant or a halophile
*make sure to standardize temperature, pH, aerobic, incubation time, and TSBYE tubes
design an experiment that will help you determine what level of oxygen your unknown will want to grow in
obtain a strict aerobe, a strict anaerobe, and a microaerobic
let the aerobe grow in normal oxygen/incubation conditions, for strict anaerobe have it grow in a GasPak (anaerobic jar with gas-generating sachets), and microanerobic prepare large glass jar with candle, have it go out, and then boom microanaerobic conditions. place the unknown in each of these conditions and then compare to the standards
*control temperature, pH, incubation time, and osmotic pressure
why do you want to control the growth of bacteria
because they can be beneficial when in the right areas, but if they are not in the right area, they can cause damage to food crops and result in infections
what is the definition of an antibiotic
chemicals naturally synthesized by living organisms
bacteriocidal vs bacteriostatic
bacteriocidial is when they kill the microbe and bacteriostatic is when the inhibit the growth of the microbe (no killing)
name three methods of physical control and how do they work/point out differences
autoclave: a chamber that uses moist heat and high pressure to create an environment that kills microbes. the steam will denature cellular proteins (leads to cell death).
incineration: dry heat to kill microbes. an example is when you take an inoculating loop at put it in a Bunsen burner.
ultraviolet light: with short UV-C (short wavelength, high energy) directly damages and denatures the DNA.
explain the molecular component of using UV light as a mean of physical control
causes doubel stranded breaks in DNA to form thymine dimers. without any repair, these lesions can inhibit DNA replication→cell death
when is it best to UV-C radiation for physical control? what is a downside?
best to sterilize surfaces and when using it for extended period of exposure
a downside is that it cannot penetrate surfaces well
in an autoclave, what is the temperature and pressure
temperature if 121 degrees C (no boiling to prevent no change of solutes in media) and pressure if 15 psi
what is the autoclave most commonly used for?
sterilizing both liquid supplies and equipment that can withstand high temperatures without melting
why is incineration not widely used?
because it can only be used on things like metal objects that can be rapidly cooled and heated (without melting)
summarize the three methods of physical control discussed in class and how they differ
autoclave uses high heat and steam to denature proteins, leading to cell death. it is pretty good to sterilize liquid and metal supplies that can withstand high heat (and autoclave time depends on size of load)
incineration uses high heat to kill microbes. this can only be used on things that can withstand high heat
UV-C: short, high energy form of radiation that breaks double stranded DNA to prevent replication, but can only be used on surfaces it can penetrate
how can we test to see if physical methods of control are working properly
autoclave: swab a dirty container before and after autoclave. standardize incubation and growth temperatures and see colony growths
incineration: take a metal inoculate tip and swab a tsaye plate. then take it again and incinerate it. swab the tsaye plate. incubate and compare microbial growth
UV exposure: swab a microbe on three plates. expose a plate to no UV, 2 seconds of UV, and 5 seconds of UV. then compare colony growth.
What is the difference between a disinfectant and antiseptic
diisinfectant=chemical that controls bacterial growth but only on inanimate objects
antiseptic=capable of doing the same thing but only on skin or living tissue
When using chemical methods of control how might the composition of the agar plate affect the effectiveness of the control measure?
components of the agar plate can affect the effectiveness of the chemical. for a TSAYE plate, the components do not really affect the chemical, but on a blood agar plate, the medium interacts with the chemicals that hinders their effectivity
How does a ‘disk diffusion assay’ work, what are indications that a compound is effective or not at control bacterial growth
basically you take a disk impregnated with a test compound and is laid on a fresh lawn of bacteria. after incubating for 24-48 hours, you can see how the chemical diffuses based on the growth trends of the microbes. it will ultimately create a zone of inhibition, but there should be the least amount of growth closest to the disk (aka the source)
what is the zone of inhbition
an area where the concentration of the chemical is too high for the cells to grow (shows intel on the diffusion of the chemical/possibly how well that chemical hinders the microbial growth.
can you compare different tests for the zone of inhibition?
no because the test depends on diffusion rates of the chemical in the plate
is the disk diffusion assay a quantitative asaay?
yes because the zone of inhibitions are based on diffusion properties of the plate rather than comparing chemicals and making conclusions on efficacy of controlling microbial growth
How does the size of the ZOI in a disk diffusion assay relate to the strength of the control compound?
you can say either that the larger the ZOI the higher the toxicity, but you can also make conclusions on the diffusing abilities of the chemical
describe diffusion in the context of this assay
how well the chemical permeates through the medium while also maintaining a high enough concentration to inhibit microbial growth
define chemical efficacy
how potent or efficient the chemical is at destroying or inhibiting microbial growth
How can we test to determine if chemical compounds are effective at controlling microbial growth?
look at the zone of inhibition=the larger mean the=higherIs the disk diffusion=greater the controlling abilities
Is the disk diffusion assay standardized? Meaning would you expect to receive the exact same results if repeated a different day, or by a different student? if not, what is different?
no, you would not get the same results because it all depends on chemical diffusion + there is little definition/specificity in the amount of compound on the disk, amount of solvent the compound was dissolved in, disk size, etx.
how do antibiotics differ from chemical compounds
antibiotics are biologically synthesized compounds that have antimicrobial properties (key word: biologically synthesized rather than synthetically made via man)
What is the name of the specialty agar that is used to perform the Kirby-Bauer assay? Why do we use this type of agar in this assay?
name: Mueller-Hinton (MH) agar plates
why?→it is a non-selective media that can support the growth of a variety of organisms, it is a loose agar (lower concentration of agar) so antibiotics can easily diffuse through, it can be easily made in labs, and contains starch to help “neutralize” the effects of any toxins produced by contained microbes (preventing interference of antibiotic on microbes)
are Kirby-Bauer assays standardized or quantitative
yes to both. it is standardized because we have defined test conditions (standard disk size and antibiotic dose)
it is quantitative because these standard conditions allow us to make conclusions about antibiotics and it generates results that can be compared form one day to another and a location from another
what conclusion can we make about microbes and an antibiotic with Kirby-Bauer assay?
you can tell whether or not a microbe is resistant, (intermediate), or sensitive/susceptible to the antibiotic
How is the zone of inhibition measured in the Kirby-Bauer assay?
can either measure edge to edge of the zone of inhibition
OR
you can measure the middle to the end and multiply times 2
and units of mm

how to interpret the results of a Kirby-Bauer assay
once you have measured the zone of inhibition, look at a reference table of antibiotic sensitivity standards. there should be an antibiotic list with different ZOIs depending on resistant, intermediate, and sensitivity.
if you ZOI ends up in the near the R value, your microbe is resistant to that antibiotic (still can grow in the presence of the microbe)
if your ZOI ends up in the I, it is intermediate ZOI value, your microbe is intermediately resistant (aka not fully killed or growth inhibited but still not resistant)
if your ZOI ends up in the S, it is susceptible, the microbe is effectively killed or inhibited by the antibiotic
what do R, I, or S classifications mean biologically?
R=resistant→will grow in the presence of antibiotic
I=intermediate→not fully inhibited or killed by antibiotic
S=sensitive→fully killed or inhibited by the antibiotic
are the ZOI for each antibiotic the same?
no, they are not the same because it depends on how well the antibiotic diffuses through the agar and the potency of the antibiotic to microbes (some antibiotics are more potent to microbes than others/some antibiotics target a specific mechanism, like cell wall synthesis, than others which can affect ZOI especially if you have a mixture of microbes)
name five food products that rely on microbial fermentation
wine, beer, kimchi, sauerkraut, and yogurt (and bread)
what are some potential negative consequences of using microbes in our foods
food spoilage (health hazard and waste of consumer money)
what cardinal temperature classification describes most pathogenic microbes? are there exceptions?
most are mesophiles so they will optimally grow between 20 and 40/45 degrees C
*note some can be thermophiles (50-70 degrees C and psychrotrophs: -20-10 degrees C
What are two methods to prevent unwanted microbial growth? How do these methods function to prevent microbial growth? Would you consider each method as bacteriostatic or bactericidal?
two methods to prevent unwanted microbial growth are pasteurization and refrigeration
pastuerization: heating for a short period prior to cooling (goal: reduce the abundance of microbes present but will not remove all; more bactericidal)
refrigeration: placing at a cool temperature to reduce metabolic activity and organismal growth rate (will act as a bacteriostatic so inhibiting growth instead of killing)
Why might the pasteurization and refrigeration not properly prevent unwanted microbial growth? What would be the cardinal terms associated with these microbes that can still grow when the method is properly implemented?
because some pathogenic microbes are not mesophiles, so are psychrotophs and thermophiles
thermophiles grow at 50-70 degrees C and can sporulate and cause health issues
psychrotrophs grow between -20 and 10 degrees so they can still grow in regrigeration conditions, leading to food spoilage and potential health problems to humans when ingested
What are two characteristic bacterium in the production of yogurt? What do these bacteria do in yogurt and is there a taste profile associated with their presence
the two bacterium are Streptococcus thermophilus and Lactobacillus bulgaricus
*these bacteria ferment lactose in milk to lactic acid, leading to the sour taste in yogurt
Which types of microbes (Gram + or -) are often found in sauerkraut or yogurt?
predominately gram positive (lactic acid bacteria in both), but we did notice some gram-negative bacteria in our sauerkraut (could be from contamination)
what were the shapes of the gram positive bacteria in your gram stain of yogurt and sauerkraut? so what bacteria was present?
gram-positive rods, so it was Lactobacillus present
define culture media/what are the three categories
different growth medias that nutrient-rich liquids or agar that support the growth, survival, and reproduction of microbes
the three types are selective, differential, and selective-differential (so you can change the culture medias to gain info about microbes or select for the growth of some microbes)
define selective media
selective media is when we are selecting for the growth of organisms with specific metabolic capabilities (so inhibiting the growth of microbes that do not have this metabolic activity)
what are the two selectivity approaches?
use a growth inhibitor (ex: antibiotics, dyes, bile salts, or other toxic compounds) to prevent the growth of microbes that cannot survive in the presence of that compound
use a selective media that contains the compounds the microbes need to grow (ex: adding a carbon or energy source that only some bacteria with that specific metabolic function can use)
what is differential media
if there is some visible distinction that allows the observer to distinguish two bacteria (gives another insight about the bacteria rather than just growth). usually all bacteria will grow, but there will be some visual distinction (like a color change) that will convey a specific aspect about a microbe
give an example of a differential media-not an official one but just a general example
some microbes have certain metabolic activities of converting sugars to acids) and you can use a pH indiciator that will have a color change if the microbes have this specific metabolic activity
what is selective-differential media
when only a select range of microbes can grow while also having visibly distinctions of different biochemical properties (ex: agar selecting for growth of gram-negative bacteria and differentiates for lactose fermenters by having pink colonies rather non fermenters which will be colorless)
is phenol red differential or selective
differential→it changes color from red/pink to yellow when bacteria ferment the carbohydrates; it does not inhibit microbial growth
is bile selective or differential
bile is both selective and differential. it inhibits gram-positive bacteria growth but turns black when it metabolizes ingredients like esculin (turns black(
are red blood cells selective or differential
they are differential because they can differentiate bacteria that can break down RBCs (either partially or completely and has a color change for each); it does not inhibit bacterial growth
are colistin and nalidixic acid selective or differential?
selective (in CNA) to inhbiti gram-negative growth and select for gram-positive organisms
is ferric citrate selective or differential
differential because there is a color change (dark brown or black precipitate) to differentiate production of hydrogen sulfide of hydrolysis of esculin
is 7.5% NaCl selective or differential
selective because it selects for halotolerant bacteria
is it selective-differential, differential, or selective: Bile Esculin Agar (BEA)
selective-differential: bile salts inhibit gram positive growth while ferric citrate differentiates for microbes that can hydrolyze esculin (turns black)
is it selective-differential, differential, or selective: Columbia Blood Agar (CNA)
selective-differential
selects for growth of gram positive (inhibits gram negative) via colisitn and nalidixic acid
differentiates microbes that can synthesize red blood cells
partial→green
total→clear medium
red→no change (will not lyse but sitll gram positive bc it can grow)
is it selective-differential, differential, or selective: Mannitol Salt Agar (MSA)
selective-differential
selects for halotolerant microbes (via NaCl) and differentiates with phenol red (if it can ferment mannitol→yellow media
red media→cannot ferment mannitol + unlikely to be pathogenic)
which culture medias can distinguish between gram + bacteria
BEA will select AGAINST gram positive (so it differentiates gram negatives ability to hydrolyze esculin)
CNA selects FOR gram positive (so it differentiates gram positive) and its ability to synthesize red blood cells
Be able to design an experiment to identify an unknown gram-positive microbe
use CNA plate because this selects for gram positive
it can at least tell you whether or not your gram positive bacteria can synthesize/lyse red blood cells
to get more info, i would do a MSA plate as well. it can tell you if your gram positive bacteria is halotolerant and whether it can synthesize mannitol (which gives an indication to its pathogenecity)
where in the body are most microbes found
in the large intestines (colon)
What type of oxygen requirements are found in that location, and what is the cardinal term associated with it.
anaerobic conditions (anaerobic)
define enterobacteria
gram negative bacteria that do not form spores (includes bacteria in normal microbiota and intestinal pathogens)
why do you want to distinguish Salmonella enterica from other microbes?
because it will help you accurately diagnose infections and determine the proper antibiotic treatment
describe how MacConkey Agar is selective and differential (mention the indicators and inhbitiors)
indicator: neutral red
inhibitor: crystal violet and bile salts that are toxic to gram + bacteria
selective differential
selects FOR gram negative bacteria
differential: pink colonies: gram negative bacteria that ferment lactose to acids
colorless colonies: do not ferment lactose
describe how Eosin Methylene Blue Agar (EMB) is selective and differential (mention indicators and inhbitiors)
indicator: methylene blue and eosin Y
inhibitior: methylene blue, which is toxic to gram positive bacteria
selective: selects for gram negative bacteria with the inhibitor
differential: if there is growth with pink, purple, or black colonies with a metallic sheen: this gram negative bacteria ferments lactose to acid (and pink-purple=pH range of 4.8.-7 while black is less than or equal to a pH of 4.8)
colorless: does not ferment lactose to acids
interpret the results from this photo
MAC plate:
1 + 2 are gram negative while 4+3 must be gram positive
1 and 2 cannot ferment lactose (no color change)
5=there is growth (gram negative) and a color change to pink=ferments lactose to acids
6=growth but no color change so does not ferment lactose to acids
unknown A is gram negative and ferments lactose
unknown B does not ferment lactose but is gram negative
EMB:
1+2 are gram negative and does not ferment lactose to acids
3+4 are gram positive
5 is gram negative and can ferment lactose to acids (green may mean pH of less than or equal to 4.8)
6 is gram negative but cannot ferment lactose to acids (no color change)
unknown A is gram negative and can ferment lactose to acids
unknown B is gram negative and cannot ferment lactose to acids
Be able to design an experiment to identify an unknown gram-negative microbe
use an EMB plate or MAC plate because these select for gram negative bacteria
then you can see if it can ferment lactose to acids on if there is a color change on either
what do letters in the IMViC test stand for
I=indole production
M=methyl red test
V=Voges-Proskauer test
C=citrate test
why should we use the IMViC series?
it helps you differentiate coliforms, which are a group of bacteria found in the environment and feces of warm-blooded animals
We will be using it to differentiate Enterbacter aerogens (found in soil) and Escherichia coli (found in feces of warm-blooded animals)
How is the indole test performed, what are the potential results of the test, and what does it indicate biologically?
cells will be grown in tryptone broth on on Day 2 indole can be detected with the addition Kovac’s reagent
possible results: if present: there will be a red ring on the surface of the medium. if not, Kovac’s reagent will remain yellow/brown
biological meaning: some microbes have an enzyme (tryptophanase) that hydrolyzes tryptophan to indole, pyruvate, and ammonium
How is the Methyl red test performed, what are the potential results of the test, and what does it indicate biologically?
the microbe is grown in a glucose-rich environment, and then on day 2, methyl red is added (pH indicator)
potential results: if the tube is red, the pH is below 4.2 and if the tube is yellow, the pH is greater than 6.2
biological meaning: this test is looking for the production of mixed acids from glucose. if red, the acids have been produced and if not, the acids have not been produced from glucose. basically, this test is determining the bacteria’s ability to ferment glucose to yield the acid
How is the Voges-Proskauer test performed, what are the potential results of the test, and what does it indicate biologically?
how the test is performed: on day 1, the microbe is grown in glucose rich medium and day 2 alpha-naphtol followed by potassium hydroxide (KOH) and rapid mixing (wait 5-10 minutes)
results: a rust color indicates a positive result that acetylmethylcarbinol (or 2,3-butanediol) is produced=indication for a specific glucose pathway
biological implication=rust color means the bacteria can do that specific glucose pathway and no color means it cannot
How is the Citrate slant test performed, what are the potential results of the test, and what does it indicate biologically?
bacteria is streaked onto a Simmons Citrate Agar slant green slant medium and incubated at 35-37 degrees C
possible results: there is a color change from green to blue or no color change
meaning: color change means the bacteria produced citrate permease so it can use citrate as its sole carbon source. no color change means that the microbe cannot use citrate as its sole carbon source
interpret results
indole
red→produces indole
no color→no indole
MR
color change: produces the acid
PV
color change: produces that specific acid (acetoin)
citrateL
blue: uses citrate as sole carbon source

describe some of the environmental conditions associated with the different regions of skin
dry, acidic, and high concentration of salt
and moist environments
what kind of bacteria are in constantly moist environments (under arms and between toes)
Gram-positive bacteria: Staphylococcus epidermidis and Micrococcus luteus
what oxygen conditions do skin surface microbes need? what about acne associated ones?
they need oxygen for skin surface ones
acne associated ones: low oxygen environments in pores (Propionibacterium acnes)
describe environmental conditions of nose and example of bacteria that colonizes this area
higher moisture content, warmer temperatures, and needs oxygen
S. aureus is found there
Describe some of the environmental conditions associated with the mouth and throat.
warm, moist, nutrient rich, high oxygen availability (but some anaerobic conditions), and neutral to slightly acidic pH
What types of microbes are commonly associated with the mouth and throat?
ex: S. mitis and S salivarius
What is BAP culture media (aka selective, differential, or both)? What indicator is used? Be able to pair observations and interpretations with this type of culture media
there are no inhibitors. only an indicator, so it is differential (aka you can see a different property besides growth)
the indicator is red blood cells
observations:
if there is a green color: partial lysis
clear medium: total lysis
red medium/no color change: no lysus